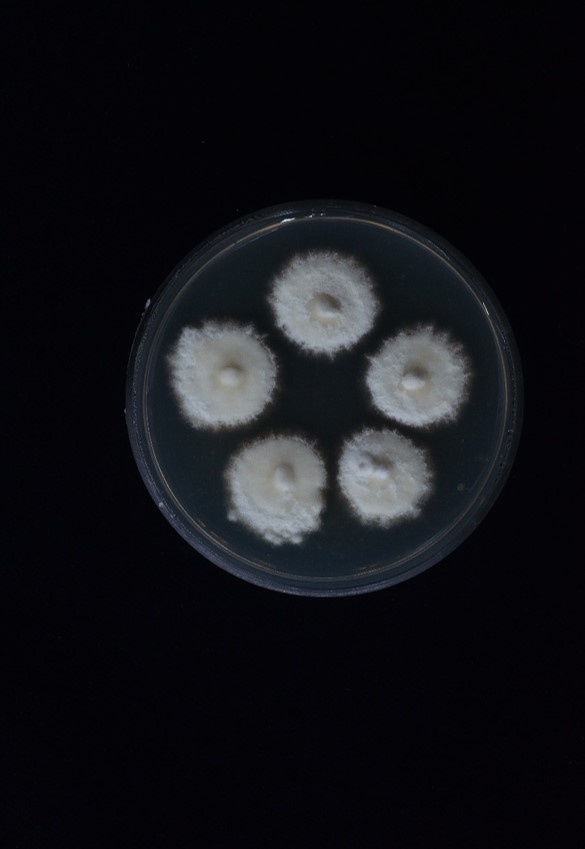

Description:
 Spider host covered by white mycelial mat.
Spider host covered by white mycelial mat.  Synnemata cylindrical, attenuated, in groups of 2–3, white to brownish white.
Synnemata cylindrical, attenuated, in groups of 2–3, white to brownish white.  Conidiophores arising laterally from the outer layer of synnemata and directly from the mycelial mat covering the host, scattered, septate, roughed, 225–280 × 7.5–12 µm, terminating in a swollen vesicle.
Conidiophores arising laterally from the outer layer of synnemata and directly from the mycelial mat covering the host, scattered, septate, roughed, 225–280 × 7.5–12 µm, terminating in a swollen vesicle.  Conidial heads spherical, 28–40 µm diam. Vesicles subglobose to globose, 4–6 µm diam. Metulae broadly obovoid, 5–9 × 3–6 µm. Phialides borne on metulae, broadly cylindrical to clavate, 5–10 × 2–3 µm, bearing a conidium.
Conidial heads spherical, 28–40 µm diam. Vesicles subglobose to globose, 4–6 µm diam. Metulae broadly obovoid, 5–9 × 3–6 µm. Phialides borne on metulae, broadly cylindrical to clavate, 5–10 × 2–3 µm, bearing a conidium.  Conidia narrowly ellipsoid, 3–5 × 2 µm.
Conidia narrowly ellipsoid, 3–5 × 2 µm.  Granulomanus synasexual morph present, occurring on the synnemata or the mycelial mat covering the host, forming conidiophores or branched hyphae bearing polyblastic, irregularly shaped phialides. Conidiophores septate, roughened, 39.5–44.5 × 5–6 µm, abruptly narrowing toward the apex, forming a vesicle. Vesicles obovoid, 7.5 µm diam. Metulae broadly obovoid or irregularly shaped, 7.5 × 6 µm. Phialides broad cylindrical to clavate, 6–11.5 × 3.5–4 µm, developing multiple denticles, each bearing a filiform conidium, 6–23 × 1 µm.
Granulomanus synasexual morph present, occurring on the synnemata or the mycelial mat covering the host, forming conidiophores or branched hyphae bearing polyblastic, irregularly shaped phialides. Conidiophores septate, roughened, 39.5–44.5 × 5–6 µm, abruptly narrowing toward the apex, forming a vesicle. Vesicles obovoid, 7.5 µm diam. Metulae broadly obovoid or irregularly shaped, 7.5 × 6 µm. Phialides broad cylindrical to clavate, 6–11.5 × 3.5–4 µm, developing multiple denticles, each bearing a filiform conidium, 6–23 × 1 µm.
Culture characteristics:
Colonies on PDA attaining a diam of 1.7 cm in 28 d at 25 ºC, floccose, forming irregular margin, white to yellowish-white, reverse light brown, darkening towards the centre with age. Sporulation occurring after a month, forming
Colonies on PDA attaining a diam of 1.7 cm in 28 d at 25 ºC, floccose, forming irregular margin, white to yellowish-white, reverse light brown, darkening towards the centre with age. Sporulation occurring after a month, forming  synnemata in a circle, powdery, brownish grey. Synnemata composed of loose hyphae, white, becoming yellowish white toward base, cylindrical, tapered toward the apex, curved. Conidiophores crowded, septate, roughened, 192–239 × 5–9 µm. Conidial heads spherical, 27–35 µm diam. Vesicles spherical, 7–10 µm diam. Metulae borne on vesicle, obovoid, 5–10 × 4–6 µm, bearing multiple phialides. Phialides broad cylindrical to clavate, 5–8 × 2–3 µm. Conidia narrow ellipsoid, 3–5 × 1–2 µm.
synnemata in a circle, powdery, brownish grey. Synnemata composed of loose hyphae, white, becoming yellowish white toward base, cylindrical, tapered toward the apex, curved. Conidiophores crowded, septate, roughened, 192–239 × 5–9 µm. Conidial heads spherical, 27–35 µm diam. Vesicles spherical, 7–10 µm diam. Metulae borne on vesicle, obovoid, 5–10 × 4–6 µm, bearing multiple phialides. Phialides broad cylindrical to clavate, 5–8 × 2–3 µm. Conidia narrow ellipsoid, 3–5 × 1–2 µm.
Reference:
Kuephadungphan W, Petcharad B, Tasanathai K, et al. (2022). Multi-locus phylogeny unmasks hidden species within the specialised spider-parasitic fungus, Gibellula (Hypocreales, Cordycipitaceae) in Thailand. Studies in Mycology101: 245–286.
DOI: https://doi.org/10.3114/sim.2022.101.04.Species |
Strain |
Compound |
Pubchem CID |
Biological activity |
Reference |
|---|
|
Strain |
ITS | LSU | RPB1 | RPB2 | TEF1 |
|---|---|---|---|---|---|
| BCC 45112 | OK040738 | OK040713 | OK040723 | - | OK040705 |
| BCC 46590 | MH532883 | MH394678 | MH521803 | MH521866 | - |